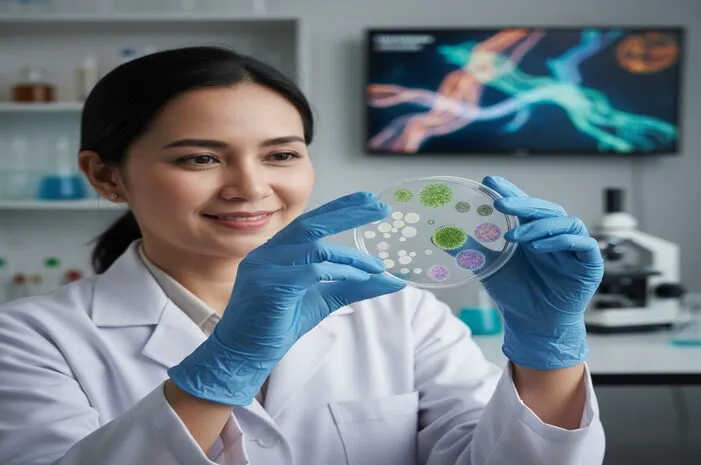
Mikroba: Ukuran, Jenis, Peran, dan Pengaruhnya

Mikroba: Jenis, Peran, dan Pengaruhnya Bagi Kita
Apa Itu Mikroba? Definisi dan Peranannya dalam Kehidupan
Mikroba, atau sering disebut mikroorganisme, adalah makhluk hidup yang berukuran sangat kecil sehingga tidak dapat dilihat dengan mata telanjang. Untuk mengamatinya, diperlukan alat bantu seperti mikroskop.
Mikroba meliputi berbagai jenis organisme seperti bakteri, virus, jamur, protista, dan archaea. Mereka dapat ditemukan di berbagai lingkungan, mulai dari tanah, air, udara, hingga di dalam tubuh manusia dan hewan.
Keberadaan mikroba sangat penting dalam ekosistem dan kehidupan sehari-hari, karena mereka dapat berperan baik secara menguntungkan maupun merugikan.
Jenis-Jenis Mikroba dan Karakteristiknya
Terdapat beberapa jenis mikroba yang perlu diketahui, antara lain:
- Bakteri: Organisme bersel tunggal yang sangat beragam dan dapat ditemukan di hampir semua lingkungan.
- Virus: Entitas biologis yang lebih kecil dari bakteri dan membutuhkan sel inang untuk bereplikasi. Virus seringkali menjadi penyebab penyakit.
- Jamur: Organisme eukariotik yang mencakup ragi, kapang, dan cendawan. Beberapa jamur berperan penting dalam fermentasi makanan.
- Protista: Kelompok organisme eukariotik yang beragam, termasuk protozoa dan alga mikroskopis.
- Arkea: Mirip dengan bakteri, tetapi memiliki perbedaan genetik dan biokimia yang signifikan. Sering ditemukan di lingkungan ekstrem seperti mata air panas atau lingkungan dengan kadar garam tinggi.
Peran Mikroba dalam Kehidupan Sehari-hari
Mikroba memiliki peran yang sangat beragam, baik yang menguntungkan maupun merugikan. Berikut adalah beberapa contohnya:
Peran Menguntungkan Mikroba
- Pencernaan Makanan: Bakteri baik dalam usus membantu mencerna makanan dan menghasilkan nutrisi penting.
- Produksi Makanan Fermentasi: Mikroba digunakan dalam pembuatan makanan fermentasi seperti tempe, yogurt, keju, dan kimchi.
- Pengurai Sampah Organik: Mikroba membantu mengurai sampah organik menjadi bahan yang lebih sederhana dan ramah lingkungan.
- Menjaga Kesehatan Usus: Probiotik, yang merupakan mikroba hidup, dapat membantu menjaga keseimbangan bakteri baik dalam usus.
Peran Merugikan Mikroba
- Penyebab Penyakit Menular: Beberapa mikroba, seperti virus dan bakteri patogen, dapat menyebabkan penyakit menular seperti flu, tuberkulosis (TBC), dan HIV/AIDS.
- Pembusukan Makanan: Mikroba dapat menyebabkan pembusukan makanan, sehingga makanan menjadi tidak layak konsumsi.
Dampak Mikroba pada Kesehatan Manusia
Mikroba memiliki dampak yang signifikan terhadap kesehatan manusia. Keseimbangan mikroba dalam tubuh, terutama di usus (mikrobiota usus), sangat penting untuk menjaga kesehatan secara keseluruhan.
Ketidakseimbangan mikrobiota usus dapat menyebabkan berbagai masalah kesehatan, seperti gangguan pencernaan, penyakit autoimun, dan bahkan masalah mental.
Oleh karena itu, menjaga keseimbangan mikrobiota usus dengan mengonsumsi makanan sehat, probiotik, dan menghindari penggunaan antibiotik yang berlebihan sangat penting untuk menjaga kesehatan.
Cara Mencegah Infeksi Mikroba Berbahaya
Mengingat beberapa mikroba dapat menyebabkan penyakit, penting untuk mengambil langkah-langkah pencegahan, antara lain:
- Menjaga Kebersihan Diri: Cuci tangan secara teratur dengan sabun dan air, terutama sebelum makan dan setelah menggunakan toilet.
- Vaksinasi: Vaksinasi dapat melindungi tubuh dari infeksi virus dan bakteri tertentu.
- Menjaga Kebersihan Lingkungan: Bersihkan lingkungan sekitar secara teratur untuk mencegah penyebaran mikroba berbahaya.
- Konsumsi Makanan yang Aman: Pastikan makanan yang dikonsumsi telah dimasak dengan benar dan disimpan dengan baik untuk mencegah kontaminasi mikroba.
Kesimpulan
Mikroba adalah bagian integral dari kehidupan kita. Memahami peran dan jenis-jenisnya membantu kita untuk lebih bijak dalam menjaga kesehatan dan lingkungan. Dengan menjaga kebersihan diri, lingkungan, dan mengonsumsi makanan yang sehat, kita dapat meminimalkan risiko infeksi mikroba berbahaya dan memaksimalkan manfaat dari mikroba yang menguntungkan.
Jika memiliki pertanyaan lebih lanjut mengenai mikroba dan dampaknya pada kesehatan, jangan ragu untuk berkonsultasi dengan dokter di Halodoc.



